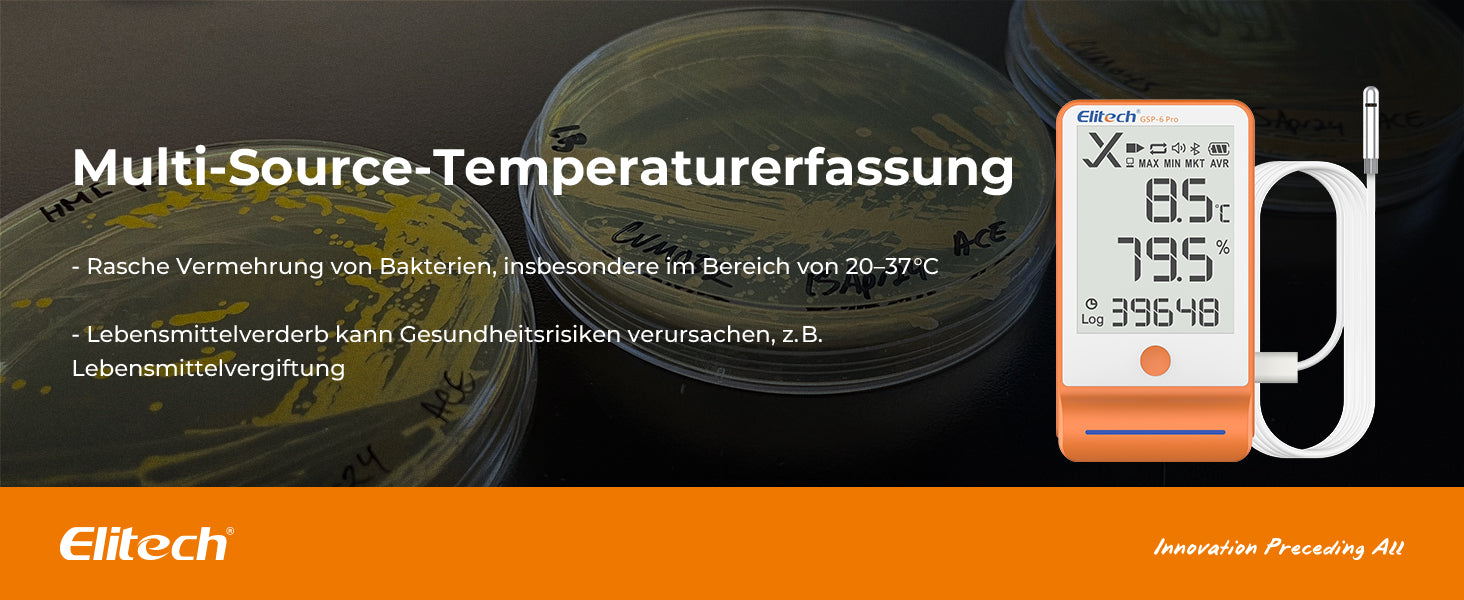

1
/
von
5
Elitech GSP-6Pro TE&THE Bluetooth Temperatur- und Feuchtigkeits-Datenlogger mit Kalibrierzertifikat, 100.000 Messpunkte, Shadow Data
Elitech GSP-6Pro TE&THE Bluetooth Temperatur- und Feuchtigkeits-Datenlogger mit Kalibrierzertifikat, 100.000 Messpunkte, Shadow Data
SKU:GSP-6Pro TE & THE
2 reviews
Normaler Preis
€45,48 EUR
Normaler Preis
€73,92 EUR
Verkaufspreis
€45,48 EUR
Stückpreis
/
pro
inkl. MwSt.
Versand wird beim Checkout berechnet
Verfügbarkeit für Abholungen konnte nicht geladen werden
Aktie

C
Christoph Menke Funktioniert tadelos
K
Klaus Ullrich Bin sehr zufrieden-leicht verständliche Software-magnetische Rückseite.





